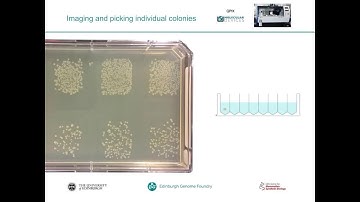
Colony Picking in a Fully Automated DNA Assembly Workflow

⬇ DOWNLOAD NOW
Jika muncul iklan pop-up, tutup lalu klik tombol kembali
Download lagu Yuan, Tekotte and Zulkower - Colony picking in a fully automated DNA assembly workflow secara gratis hanya untuk keperluan promosi. Dukung artis favorit kamu dengan membeli musik original di iTunes atau platform resmi lainnya.
Colony Picking in a Fully Automated DNA Assembly Workflow
Colony Picking in a Fully Automated DNA Assembly Workflow Advanced Workflow Engineering Solutions Molecular Devices
Advanced Workflow Engineering Solutions Molecular Devices Robotic Colony Picking with QPix2 Close Up
Robotic Colony Picking with QPix2 Close Up Colony pickers QPix colony picking; bacterial colonies, yeast colony
Colony pickers QPix colony picking; bacterial colonies, yeast colony Altec- Advanced Lab Automation
Altec- Advanced Lab Automation Automated colony picking
Automated colony picking Automated picking of E.coli colonies from agar plates
Automated picking of E.coli colonies from agar plates Earlham Institute Bio Foundry - Automated colony picking
Earlham Institute Bio Foundry - Automated colony picking